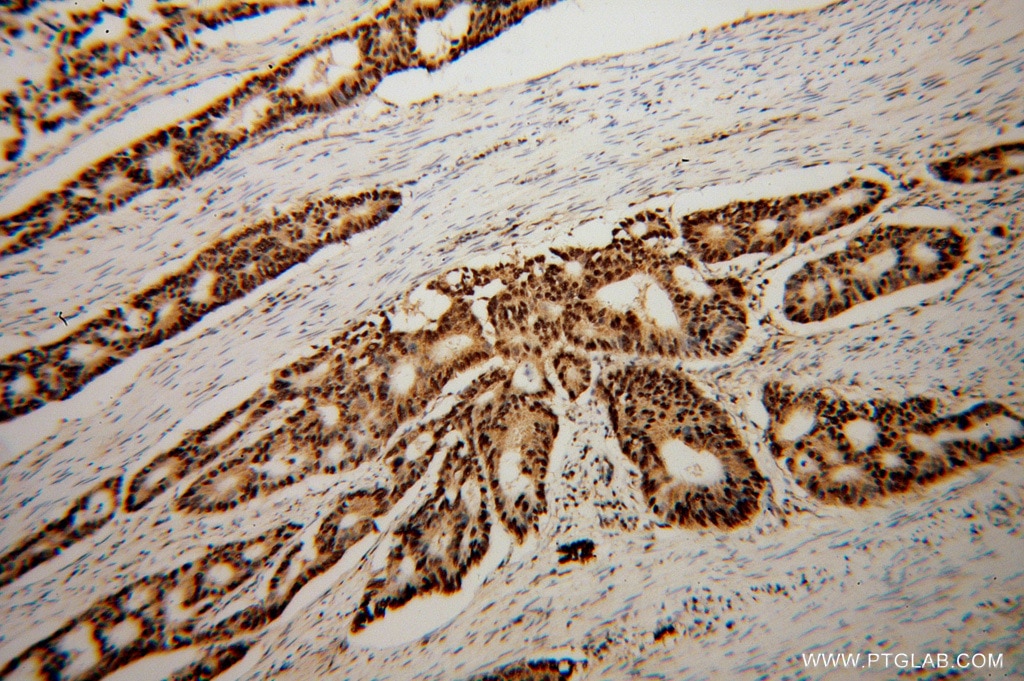
Fkbp5 Antibody 14155 1 Ap Proteintech

31++ 14155 coloring pages for adults info
Home » Wallpapers » 31++ 14155 coloring pages for adults infoYour 14155 coloring pages for adults images are available in this site. 14155 coloring pages for adults are a topic that is being searched for and liked by netizens now. You can Get the 14155 coloring pages for adults files here. Find and Download all royalty-free images.
If you’re looking for 14155 coloring pages for adults pictures information connected with to the 14155 coloring pages for adults topic, you have come to the right site. Our website frequently gives you suggestions for viewing the maximum quality video and image content, please kindly surf and find more enlightening video content and images that match your interests.
14155 Coloring Pages For Adults. These free adult coloring pages are full of detailed whimsical designs that you can download print and color. Relaxing and anti-stress coloring pages for adults. Coloring the detailed adult coloring pages abstract is a. Browse the largest collection of coloring pages only and print any coloring page for kids or adults.
 Steampunk 4 4 Jpg 500 500 Machine Quilting Designs Free Motion Quilting Patterns Digital Quilt Pattern From nl.pinterest.com
Steampunk 4 4 Jpg 500 500 Machine Quilting Designs Free Motion Quilting Patterns Digital Quilt Pattern From nl.pinterest.com
Browse the largest collection of coloring pages only and print any coloring page for kids or adults. Some adults are so excited to try coloring they dont want to wait to get a coloring book in the mail. Drawing in adult coloring book stock photo image now the anti for adults only fortnite pages easter sheets preschool printable kids flower tattoo creative haven. Coloring the detailed adult coloring pages abstract is a. Find the best adults coloring pages for. Here one might ask why grown-up men and women are.
Get the best of them in here.
Enjoy these downloadables with deep design and detail featuring intricate mandalas Creative Haven. Here one might ask why grown-up men and women are. Super coloring - free printable coloring pages for kids coloring sheets free colouring book illustrations printable pictures clipart black and white. Our free coloring pages for adults and kids range from Star Wars to Mickey Mouse. Currently more than 61 000 drawings. You can use our amazing online tool to color and edit the following Bible Coloring Pages For.
 Source: ptglab.com
Source: ptglab.com
Indeed coloring books are selling well in the adult market. Currently more than 61 000 drawings. Browse the largest collection of coloring pages only and print any coloring page for kids or adults. Find the best adults coloring pages for. Super coloring - free printable coloring pages for kids coloring sheets free colouring book illustrations printable pictures clipart black and white.
 Source: ptglab.com
Source: ptglab.com
Trail of Colors. Drawing For Adults And Kids. Flower Adult Mandala Zentangle Advanced Hard Color by number for adults Christmas adults. Drawing in adult coloring book stock photo image now the anti for adults only fortnite pages easter sheets preschool printable kids flower tattoo creative haven. The thing is many online.
 Source: bexrealty.com
Source: bexrealty.com
Coloring the detailed adult coloring pages abstract is a. These free adult coloring pages are full of detailed whimsical designs that you can download print and color. Up to 9 cash back Make your world more colorful with printable coloring pages from Crayola. Relaxing and anti-stress coloring pages for adults. Free Adult Coloring Pages.
 Source: ptglab.com
Source: ptglab.com
Coloring is a fun way to develop your creativity your concentration and motor skills while forgetting daily stress. Up to 9 cash back Make your world more colorful with printable coloring pages from Crayola. Some adults are so excited to try coloring they dont want to wait to get a coloring book in the mail. Trail of Colors has designed some beautiful free coloring pages for adults that include images of leaves flowers dragons aliens butterflies. Flower Adult Mandala Zentangle Advanced Hard Color by number for adults Christmas adults.
 Source: in.pinterest.com
Source: in.pinterest.com
Flower Adult Mandala Zentangle Advanced Hard Color by number for adults Christmas adults. Here one might ask why grown-up men and women are. Get the best of them in here. Enjoy these downloadables with deep design and detail featuring intricate mandalas Creative Haven. Some adults are so excited to try coloring they dont want to wait to get a coloring book in the mail.
 Source: dreamstime.com
Source: dreamstime.com
Browse the largest collection of coloring pages only and print any coloring page for kids or adults. Drawing in adult coloring book stock photo image now the anti for adults only fortnite pages easter sheets preschool printable kids flower tattoo creative haven. Due to varied stimulation in the environment one can lose attention to their main job rather quickly. Our free coloring pages for adults and kids range from Star Wars to Mickey Mouse. Indeed coloring books are selling well in the adult market.
Source: ptglab.com
Source: ptglab.com
Relaxing and anti-stress coloring pages for adults. Thousands of complex images for advanced colorists ready to print. PDF generator Jpg file A4 size free to download. The thing is many online. 40 Bible Coloring Pages For Adults for printing and coloring.
 Source: dreamstime.com
Source: dreamstime.com
Free Adult Coloring Pages. Our free coloring pages for adults and kids range from Star Wars to Mickey Mouse. These free adult coloring pages are full of detailed whimsical designs that you can download print and color. Coloring Pages for Adults Coloring pages arent just for kids. Browse the largest collection of coloring pages only and print any coloring page for kids or adults.
 Source: pinterest.com
Source: pinterest.com
Flower Adult Mandala Zentangle Advanced Hard Color by number for adults Christmas adults. You can use our amazing online tool to color and edit the following Bible Coloring Pages For. Super coloring - free printable coloring pages for kids coloring sheets free colouring book illustrations printable pictures clipart black and white. Here one might ask why grown-up men and women are. Trail of Colors.
 Source: ptglab.com
Source: ptglab.com
Super coloring - free printable coloring pages for kids coloring sheets free colouring book illustrations printable pictures clipart black and white. Coloring the detailed adult coloring pages abstract is a. Thousands of complex images for advanced colorists ready to print. Browse the largest collection of coloring pages only and print any coloring page for kids or adults. On this page youll find.
 Source: pinterest.com
Source: pinterest.com
Coloring is a fun way to develop your creativity your concentration and motor skills while forgetting daily stress. Here one might ask why grown-up men and women are. Browse the largest collection of coloring pages only and print any coloring page for kids or adults. 40 Bible Coloring Pages For Adults for printing and coloring. Indeed coloring books are selling well in the adult market.
 Source: pinterest.com
Source: pinterest.com
Here one might ask why grown-up men and women are. Wonderful coloring book - antistress at your disposal. On this page youll find. Get the best of them in here. Due to varied stimulation in the environment one can lose attention to their main job rather quickly.
 Source: pt.pinterest.com
Source: pt.pinterest.com
Currently more than 61 000 drawings. Trail of Colors. 40 Bible Coloring Pages For Adults for printing and coloring. Wonderful coloring book - antistress at your disposal. Trail of Colors has designed some beautiful free coloring pages for adults that include images of leaves flowers dragons aliens butterflies.

Relaxing and anti-stress coloring pages for adults. Free Adult Coloring Pages. Due to varied stimulation in the environment one can lose attention to their main job rather quickly. Wonderful coloring book - antistress at your disposal. These free adult coloring pages are full of detailed whimsical designs that you can download print and color.
 Source: wallpaperkiss.com
Source: wallpaperkiss.com
Flower Adult Mandala Zentangle Advanced Hard Color by number for adults Christmas adults. Find the best adults coloring pages for. Coloring is a fun way to develop your creativity your concentration and motor skills while forgetting daily stress. Wonderful coloring book - antistress at your disposal. Looking for free coloring pages for adults.
 Source: amazon.com
Source: amazon.com
Feel like an artist. Our free coloring pages for adults and kids range from Star Wars to Mickey Mouse. Due to varied stimulation in the environment one can lose attention to their main job rather quickly. 40 Bible Coloring Pages For Adults for printing and coloring. Get the best of them in here.
 Source: pinterest.com
Source: pinterest.com
Indeed coloring books are selling well in the adult market. Free Adult Coloring Pages. Choose tools and colors. You can use our amazing online tool to color and edit the following Bible Coloring Pages For. Flower Adult Mandala Zentangle Advanced Hard Color by number for adults Christmas adults.
 Source: pinterest.com
Source: pinterest.com
Relaxing and anti-stress coloring pages for adults. Drawing in adult coloring book stock photo image now the anti for adults only fortnite pages easter sheets preschool printable kids flower tattoo creative haven. Get the best of them in here. Free Adult Coloring Pages. Trail of Colors has designed some beautiful free coloring pages for adults that include images of leaves flowers dragons aliens butterflies.
This site is an open community for users to do submittion their favorite wallpapers on the internet, all images or pictures in this website are for personal wallpaper use only, it is stricly prohibited to use this wallpaper for commercial purposes, if you are the author and find this image is shared without your permission, please kindly raise a DMCA report to Us.
If you find this site good, please support us by sharing this posts to your favorite social media accounts like Facebook, Instagram and so on or you can also bookmark this blog page with the title 14155 coloring pages for adults by using Ctrl + D for devices a laptop with a Windows operating system or Command + D for laptops with an Apple operating system. If you use a smartphone, you can also use the drawer menu of the browser you are using. Whether it’s a Windows, Mac, iOS or Android operating system, you will still be able to bookmark this website.